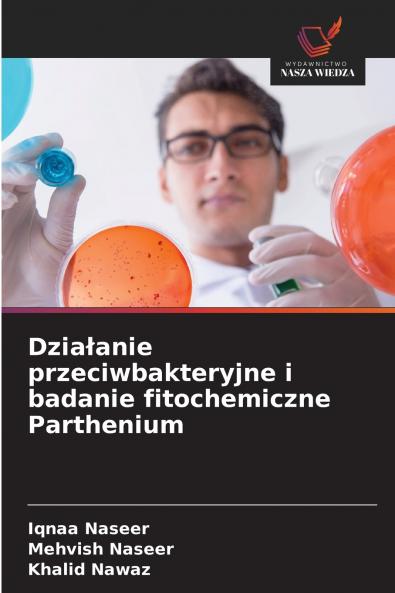
Działanie przeciwbakteryjne i badanie fitochemiczne Parthenium

Polish
Paperback
₹7788
₹10034
22.38% OFF
(All inclusive*)
Delivery Options
Please enter pincode to check delivery time.
*COD & Shipping Charges may apply on certain items.
Review final details at checkout.
Looking to place a bulk order? SUBMIT DETAILS
About The Book
Description
Author(s)
Właściwości lecznicze roślin wynikają z obecności metabolitów wtórnych które działają jak broń chroniąca organizm rośliny przed organizmami wywołującymi niepokój. Przypuszczano że Parthenium hystrophours ma przekonujące działanie przeciwbakteryjne i przeciwgrzybicze dlatego przeprowadzono niniejsze badanie w celu określenia działania przeciwbakteryjnego i przeciwgrzybiczego oraz wstępnego badania fitochemicznego tej rośliny. Roślinę poddano działaniu trzech rozpuszczalników tj. metanolu etanolu i wody po przekształceniu jej w proszek w celu przygotowania organicznych ekstraktów roślinnych. Działanie przeciwbakteryjne określono za pomocą testu dyfuzji w studzience Agera na dwunastu szczepach bakterii Escherichia coli 1 Escherichia coli 2 Escherichia coli 3 Neisseria gonorrhoeae Streptococcus pyogenes Enterobactor aerogenes Shigella sonnei Micrococcus luteus Bacillus subtilis Staphylococcus aureus 1 Staphylococcus aureus 2 i Klebsiella pneumonia. Zastosowano również bardzo nowatorski parametr który obejmował wpływ czasu na dawki ekstraktu hamujące wzrost bakterii w celu określenia skuteczności surowca roślinnego.
Delivery Options
Please enter pincode to check delivery time.
*COD & Shipping Charges may apply on certain items.
Review final details at checkout.
Details
ISBN 13
9786209311925
Publication Date
-12-12-2025
Pages
-76
Weight
-116 grams
Dimensions
-152x229x4.62 mm